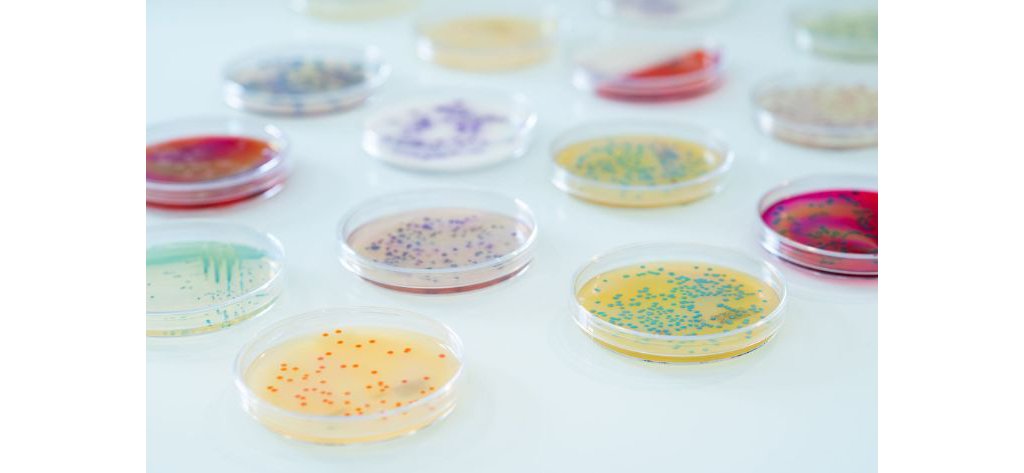

Beverage Testing
Maintaining quality throughout the process and supply chain requires fast and accurate diagnostics to identify, monitor, control, and prevent spoilage events. Innovative diagnostics solutions are essential to address these challenges.
bioMérieux creates AUGMENTED DIAGNOSTICS, a disruptive approach combining microbiology testing with Data & Genomic capabilities. This approach provides comprehensive insights throughout the production process, aiding risk anticipation, meeting consumer preferences, addressing supply chain challenges, and supporting CSR initiatives.
As a trusted partner, bioMérieux delivers solutions to improve risk management, prevent incidents, and sustain operational performance in the beverage industry.
Solutions for the Beverage Industry
-
AIR IDEAL® 3P®
Bring Confidence to your Environmental Monitoring
AIR IDEAL® 3P® is used for the detection of viable organisms through active air sampling.
-
API®
Manual Microbial Identification
API® makes microbial identification simple and reliable. Combining a standardized method with an extensive and robust digital microbial ID knowledge base, API® can easily be implemented into any microbiology laboratory.
-
APS ONE™
AUTOMATED CULTURE MEDIA PLATE POURING SYSTEM
Automated Pourer Stacker for Petri dishes – a culture media plate pouring system that makes it possible to prepare superior homemade culture media plates for high quality test results.
-
BACT/ALERT® 3D
The Method of Choice for Rapid Sterility Testing
BACT/ALERT® 3D - used by more than 80% of the top 20 big pharma companies to release pharmaceutical products, delivering fast results through a simple, efficient sterility testing workflow.
-
Culture Media
Comprehensive Control
Reliable culture media solutions safeguard food products from contamination, making them an essential part of your laboratory’s daily quality control testing while delivering high efficiency and reliability.
-
Dehydrated Culture Media for the Food Industry
FLEXIBILITY AND OPTIMAL PERFORMANCE
bioMérieux's Dehydrated Culture Media are specially formulated to offer optimal performance in various microbiological testing contexts and meet the specific requirements of the food industry.
-
GENE-UP®
Automated Pathogen Detection
GENE-UP® delivers a Real-Time PCR technology for the detection of foodborne pathogens, spoilers and viruses; simplifying training and workflow and reducing cross contamination risk.
-
MASTERCLAVE® Media Preparator
Broth and Culture Media Preparation
MASTERCLAVE® is an automated culture media preparation system that improves your laboratory workflow, from media to sample preparation.
Related Industries
Related Content
Contact Us For More Information
Every facility is different, with unique challenges, and needs. Fill out the form below and get in touch with one of our experts, who can chat with you about your current situation and get started on a tailored plan specific to your operation!